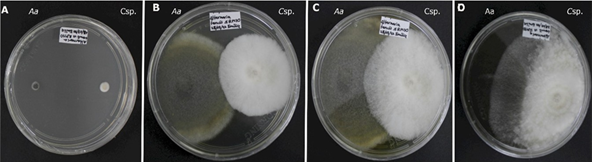
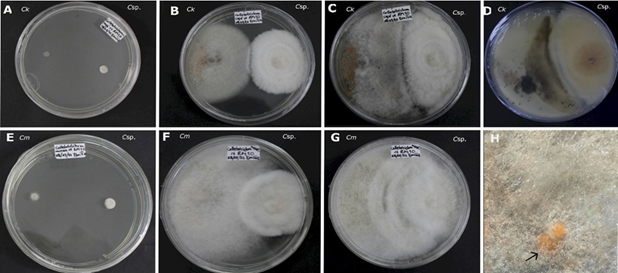
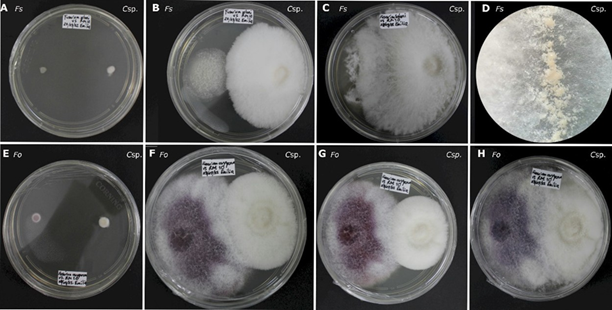

Introducción
El género Clonostachys, comprende hongos con diversos estilos de vida, incluyendo micoparásitos destructivos, que son utilizados como agentes de biocontrol de hongos patógenos de plantas y también especies con otro tipo de asociaciones ecológicas (Schroer, 2001); pocos estudios relacionados con este género se han publicado en México, aun así recientemente se citó a Clonostachys rosea parasitando aguacate en Puebla (Cóyotl-Pérez et al., 2022) y a C. chloroleuca causando marchitez de garbanzo (Cicer arietinum) en Sinaloa y Baja California (Cota-Barreras et al., 2022). De las especies micoparásitas, la más estudiada y utilizada como agente de control biológico es Clonostachys rosea (Funck y Dubey, 2022), la cual actúa contra numerosos patógenos de plantas como géneros de Alternaria, Botrytis, Bipolaris, Drechslera, Moniliophthora, Phytophthora, Rhizoctonia, Rhynchosporium y Sclerotinia (Sun et al., 2020). Como una de las alternativas para el control de enfermedades causadas por fitopatógenos, está el uso de biocontroles, mismos que se sustentan en la capacidad de ciertos grupos de hongos para inhibir el crecimiento de otros, mediante enzimas hidrolíticas como quitinasas y glucanasas, lo cual les confiere una ventaja distintiva al permitirles dirigirse hacia las hifas de otros hongos, logrando degradar de manera efectiva las paredes celulares (Moore et al., 2020). Debido a esto las investigaciones sobre este grupo de hongos son importantes para descubrir nuevas posibilidades de control biológico.
En Clonostachys se han reportado 11 especies micoparásitas (Schroers, 2001).
A la fecha no se tiene reporte de Clonostachys como micoparásito en Veracruz por lo que el objetivo del presente trabajo fue evaluar in vitro el grado de antagonismo de una cepa de Clonostachys sp. aislada frente a cinco cepas de hongos fitopatógenos: Alternaria alternata, Colletotrichum musae, C. kahawae, Fusarium oxysporum y F. solani.
Clonostachys fue aislada (Senanayake et al. 2020) como un micoparásito de un ascomiceto (Lachnum petridophyllum) habitante del bosque mesófilo de Veracruz. Para el aislamiento se utilizó medio PDA (MCD LAB), se incubó cinco días a 26 °C. La cepa está depositada en el cepario del Centro de Investigación en Micología Aplicada (CIMA) de la Universidad Veracruzana bajo la clave CIMAF-168. La cepa fue revisada al microscopio compuesto Primo Star Iled (Carl Zeiss, Oberkochen, Alemania) y se midieron los conidióforos primarios y secundarios (Schroers et al., 2001). Dado que la cepa posee características morfológicas que no corresponden con ninguna de las especies micoparásitas citadas de Clonostachys, actualmente se encuentra en proceso de identificación molecular.
De acuerdo con Comporota (1985), la primera fase para seleccionar una cepa con potencial biocontrol, es evaluar la capacidad para invadir otros hongos. Para corroborar esto se seleccionaron cinco especies de hongos asociados a enfermedades en cultivos previamente estudiados: Alternaria alternata (CIMAF-056; Trigos et al., 2008); Colletotrichum kahawae (CIMAF-078; aislada por A. Salinas de la finca de café Bola de Oro, Coatepec, Veracruz); Colletotrichum musae (CIMAF-012; donada por COLPOS); Fusarium oxysporum (CIMA-F-068; Adame et al., 2015); F. solani (CIMA-F-127; Lagunes et al., 2015), todas ellas depositadas en el cepario del CIMA-UV. Las cepas fueron sembradas en medio PDA y se incubaron en una estufa de cultivo (BGE-71) a 26 °C por siete días.
La actividad antagónica se evaluó mediante cultivos duales, colocando dos discos de 4 mm de diámetro en cajas Petri de 90 mm con medio PDA. De un lado se colocó un disco de PDA con crecimiento micelial de Clonostachys sp. y del otro lado el hongo asociado a cultivos. La distancia de separación entre discos fue de 50 mm y 15 mm separados del margen de la caja. Se hicieron cinco repeticiones para cada ensayo de confrontación.
Como control, se sembraron cada uno de los hongos evaluados sin la presencia de Clonostachys sp., y la cepa de Clonostachys sp. sin presencia de otros hongos. Tanto los controles como los cultivos duales, se incubaron a 26 ºC. Cada 24 h se tomaron medidas del crecimiento (milímetros) de ambos hongos en confrontación y del control hasta completar 360 horas (15 días).
Se observó y describió la interacción entre los hongos in vitro, con especial atención a la producción de estructuras reproductoras, pigmentación y morfología del micelio. El grado de antagonismo (Cuadro 1) se determinó con la escala de Bell et al. (1980).
Cuadro 1 Escala cualitativa del grado de antagonismo de Clonostachys sp. y los hongos asociados a enfermedades evaluados.*
| Grado | Capacidad antagónica |
|---|---|
| 1 | Clonostachys superó al hongo y cubrió toda la superficie del medio. |
| 2 | Clonostachys superó al menos 2/3 de la superficie del medio. |
| 3 | Clonostachys y el hongo colonizaron cada uno aproximadamente la mitad de la superficie del medio. |
| 4 | El hongo colonizó al menos 2/3 de la superficie del medio. |
| 5 | El hongo superó por completo a Clonostachys. |
*Modificado de Bell et al. (1980).
Con las medidas de crecimiento, se determinó el porcentaje de colonización siguiendo la fórmula de Camporota (1985): C= DT/DE/100, donde DT es la distancia recorrida por Clonostachys sp. sobre el eje que separa los puntos de siembra y DE es la distancia entre ambos (5 cm). Se consideró una colonización efectiva, cuando el porcentaje fue mayor al 50 % (Rollan et al., 1999). Los análisis estadísticos se realizaron con el software R (R Core Team). Se comprobó la normalidad de los datos con la prueba de Shapiro-Wilks. Posteriormente, se realizó un análisis GLM (modelo lineal generalizado).
La cepa en estudio presentó un comportamiento antagónico del tipo micoparásito contra las cinco especies de hongos evaluadas, de las cuales Fusarium solani corresponde a la clase 1, Alternaria alternata, Colletotrichum musae y C. kahawae a la clase 2; y Fusarium oxysporum a la clase 3, según la escala propuesta en Cuadro 1. En ninguno de los casos se presentó un halo de inhibición, por lo que la interacción observada corresponde al tipo de “sobrecrecimiento”, de acuerdo con la clasificación de Bertrand et al. (2013).
El porcentaje de colonización de Clonostachys sp. fue del 100 % a las 216 h frente a A. alternata, C. kahawae y F. solani, mientras que en las especies C. musae y F. oxysporum fueron a las 264 horas en condiciones in vitro (Cuadro 2).
Cuadro 2 Porcentaje de crecimiento de Clonostachys sp. frente a los hongos.
| Tiempo (horas) | Media A. alternata frente a Clonostachys sp. | Media del porcentaje de crecimiento de Clonostachys sp. |
|---|---|---|
| 24 | 7.2-6.4 | 12.7 |
| 72 | 25.6-21.2 | 42.0 |
| 120 | 40.7-35.6 | 69.5 |
| 168 | 45.3-45.0 | 87.8 |
| 216 | 46.5-53.8 | 100 |
| 264 | 49.4-60.8 | 100 |
| 312 | 51.8-70.6 | 100 |
| 360 | 53.2-78.0 | 100 |
| Tiempo (horas) | Media C. kahawae frente a Clonostachys sp. | Media del porcentaje de crecimiento de Clonostachys sp. |
| 24 | 4.8-7.4 | 14.7 |
| 72 | 19.9-21.6 | 43.2 |
| 120 | 40.2-36.6 | 73.2 |
| 168 | 45.8-49.6 | 99.2 |
| 216 | 50-58.8 | 100 |
| 264 | 50-65.6 | 100 |
| 312 | 50-70.8 | 100 |
| 360 | 50-76.0 | 100 |
| Tiempo (horas) | Media C. musae frente a Clonostachys sp. | Media del porcentaje de crecimiento de Clonostachys sp. |
| 24 | 6.4-7.1 | 14.2 |
| 72 | 41.8-20.7 | 41.4 |
| 120 | 46.8-35.5 | 71.0 |
| 168 | 46.8-42.3 | 84.7 |
| 216 | 46.8-48.7 | 97.3 |
| 264 | 46.8-53.1 | 100 |
| 312 | 46.8-56.7 | 100 |
| 360 | 46.8-65.8 | 100 |
| Tiempo (horas) | Media F. solani frente a Clonostachys sp. | Media del porcentaje de crecimiento de Clonostachys sp. |
| 24 | 4.5-7.4 | 14.7 |
| 72 | 15.2-21.0 | 42.0 |
| 120 | 23.2-36.6 | 73.2 |
| 168 | 30.7-45.0 | 90.0 |
| 216 | 33.3-52.8 | 100 |
| 264 | 34.0-59.4 | 100 |
| 312 | 34.9-69.2 | 100 |
| 360 | 34.9-75.0 | 100 |
| Tiempo (horas) | Media F. oxysporum frente a Clonostachys sp. | Media del porcentaje de crecimiento de Clonostachys sp. |
| 24 | 9.5-7.9 | 15.9 |
| 72 | 32.9-21.1 | 42.3 |
| 120 | 45-32.9 | 65.8 |
| 168 | 50-40.8 | 81.5 |
| 216 | 50-46.8 | 93.6 |
| 264 | 50-54.8 | 100 |
| 312 | 50-57.8 | 100 |
| 360 | 50-58.8 | 100 |
Aunque la colonización fue efectiva, no se encontraron diferencias significativas en el porcentaje de colonización entre los fitopatógenos evaluados (p= 0.0073). No obstante, el tiempo de invasión si tuvo un efecto significativo en el porcentaje de colonización para cada hongo, como lo indica el valor de p < 0.0001 obtenido en el análisis GLM.
Por otra parte, los hongos evaluados exhiben distintas tasas de crecimiento y características particulares, por ejemplo, en el caso de Alternaria alternata (Figura 1) a las 168 horas, produjo un pigmento color amarillo brillante en el medio de cultivo que se intensificó a naranja. De acuerdo con Scott y Stoltz (1980), los pigmentos amarillos difusos en el medio se relacionan con la producción de toxinas como la altertoxina II en A. alternata.
Figura 1 Antagonismo in vitro de Clonostachys sp. (Csp.) contra Alternaria alternata (Aa). A: 24 horas de la evaluación. B. 120 horas de evaluación. C. 216 horas de evaluación. D. día 15 de evaluación.
A las 144 horas en C. kahawae se apreció una pigmentación de color marrón en el centro de la colonia, esta se intensificó a medida que el antagonista crecía sobre hongo (Figura 2). Así mismo, durante la interacción entre Clonostachys sp. frente a C. musae se observó el crecimiento del antagonista sobre los acérvulos producidos por C. musae (Figura 2). Este proceso es de suma importancia, ya que puede contribuir significativamente a la interrupción del ciclo del patógeno, al formarse los acérvulos al final del ciclo de infección, al romper la cutícula de la planta para emerger y continuar con la reproducción asexual (da Silva et al., 2020).
Figura 2 Antagonismo in vitro de Clonostachys sp. (Csp.) frente a Colletotrichum kahawae (Ck) y Colletotrichum musae (Cm). A-D) Colletotrichum kahawae (Ck). A: a las 24 horas de la evaluación. B: a las 192 horas de evaluación. C: 360 horas de evaluación. D: reverso de la caja en el día 15 de evaluación. E-H) Colletotrichum musae (Cm) contra Clonostachys sp. (Csp.). E: 24 horas de la evaluación. F: 192 horas de evaluación. G: 360 horas de evaluación. H: Conidióforos de Clonostachys sp. creciendo sobre acérvulos de C. musae.
Aunque el género Clonostachys ha sido objeto de estudio en relación con su actividad antagónica, existen pocas investigaciones centradas en su interacción con las especies del género Colletotrichum. Peters et al. (2020) aislaron a Clonostachys rosea como endófito de la planta de acaí (Euterpe oleracea) y demostraron su capacidad para inhibir el crecimiento de Colletotrichum gloeosporioides, agente causal de la antracnosis. Este estudio presenta por primera vez la evaluación antagónica contra dos especies del género Colletotrichum que no habían sido evaluadas anteriormente.
En el caso de la interacción entre F. solani y Clonostachys sp. a las 168 horas, el micelio aéreo de Clonostachys sp. cambió su morfología, formando una colonia convexa con un margen fimbriado, a diferencia del testigo y los ensayos con otros hongos. Se observaron unas masas de conidios de consistencia acuosa en el margen a las 240 horas (Figura 3).
Figura 3 Antagonismo in vitro de Clonostachys sp. frente a Fusarium spp. A-D) Fusarium solani (Fs) contra Clonostachys sp. (Csp.) A: A las 24 horas de evaluación. B: a las 96 horas de evaluación. C: a las 360 horas de evaluación. D: masas de conidióforos de consistencia acuosa en el margen de Clonostachys sp. E-H) Fusarium oxysporum (Fo) contra Clonostachys sp. (Csp.) E: a las 24 horas de evaluación. F: a als 144 horas de evaluación. G: a las 192 horas de evaluación. H: a las 360 de evaluación.
Algunas de las características entre F. oxysporum y Clonostachys sp. fue que a las 168 horas, ambos alcanzaron a colonizar la mitad de la caja Petri, con los márgenes tocándose. Durante este periodo, los pigmentos de F. oxysporum se intensificaron, cambiando de un color lila al inicio del ensayo a un color morado intenso en el centro con márgenes claros al finalizar el experimento, manteniendo la misma coloración que el testigo (Figura 3).
Algunos trabajos realizados con los mismos géneros probados en este ensayo, mostraron que la actividad antagónica in vitro e in vivo de 10 cepas de Clonostachys y F. circinatum en plántulas de Pinus radiata (Moraga et al., 2011) fue variable, donde las cepas inhibieron a F. circinatum hasta un 23 % en condiciones in vitro, no así en los ensayos in vivo, donde el porcentaje de supervivencia de las plántulas infectas por el hongo aumentó. También se ha demostrado que las enzimas endoquitinasas, participan en el proceso de degradación de las paredes celulares de especies como Fusarium culmorum (Mamarabadi et al., 2008).
Las interacciones observadas entre Clonostachys sp. y los hongos en estudio presentaron características distintivas, como la producción de masas de conidios y una morfología de micelio diferente durante el ensayo, particularmente en F. solani. Además, se registró una variación en la velocidad de invasión en cada hongo evaluado. Estas diferencias pueden atribuirse a factores como la regulación transcriptómica y la capacidad de Clonostachys para discriminar entre las especies que va a micoparasitar, como sucede en el caso de C. rosea (Nygren et al., 2018).
Los ensayos duales para comprobar el efecto antagónico de las especies a nivel in vitro constituyen la base para buscar mejores candidatos para el control biológico de hongos causantes de enfermedades en cultivos de importancia económica. Dada la marcada actividad de la cepa de Clonostachys sp. frente a todos los hongos evaluados, esta se perfila como un buen candidato para futuras investigaciones para evaluar su efectividad in vivo.











 text in
text in 


